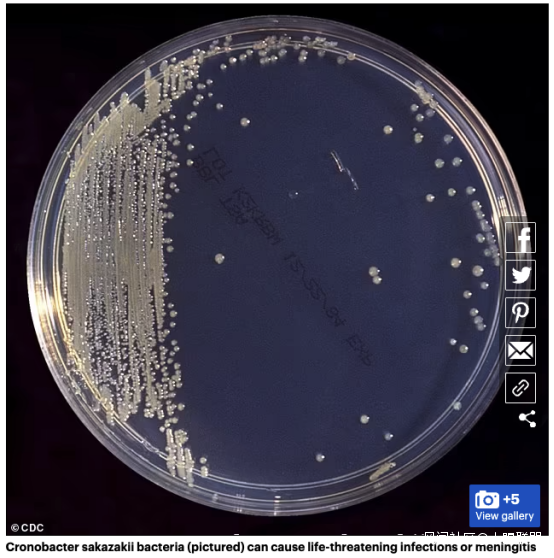

簡直低級!FDA嚴查雅培奶粉致死事件!在生產車間發現了更大的問題_風聞
大眼联盟-2022-03-26 08:46
雅培問題奶粉被召回的事件已經持續發酵了一個月,大家最初都以為僅僅是批次的質量問題,殊不知,背後生產工廠的問題更加嚴重!
FDA終於伸手嚴查雅培公司!


01
FDA伸手嚴查雅培奶粉
美國食品和藥物管理局(FDA)在1月31日至3月18日期間,對雅培公司(Abbott Nutrition)生產工廠進行了檢查,發現該公司生產工廠衞生條件未能達標,不能確保配方奶在生產過程中不受污染。
今天,根據美國食品和藥物管理局(FDA)發佈的長達29頁的最新FDA表格483文件中可以看到,2019年、2021年和2022年對雅培密歇根州斯特吉斯工廠(Sturgis)進行檢查結果表明,生產工廠存在很大的問題。
報告中寫滿了該工廠到處都可以檢測到克羅諾桿菌的致命細菌****(包括****坂崎克羅諾桿菌******)**。(FDA給出的表格483並不代表該機構對有可能違規行為的最終判決。)

FDA最近幾週報告稱,從今年1月到3月初的檢查中,發現環境樣本中的檢測坂崎克羅諾桿菌結果為陽性****,這種細菌是導致至少5名嬰兒患病。
更可怕的是,嬰兒的死亡和患病數量仍在增加,繼2021年9月報道第一例患病嬰兒後,目前已經增加到2名嬰兒死亡病例。(死亡原因仍在調查中)
2名嬰兒的死亡代表着兩個家庭陷入了無盡的悲痛之中。
FDA發佈的報告中,每一頁都牽動着無數母親的心,這裏面詳細記錄了生產奶粉工廠的每一個角落。

在2022年的調查中,雅培公司代表表示,該公司此前生產工廠中發現了克羅諾桿菌,但並未在成品嬰兒配方奶粉樣品中發現。但此次FDA給出的調查結果中可以看到,在生產嬰兒配方奶粉中度和高度的護理區表面存在克羅諾桿菌****。
02
雅培生產車間哪裏被查出問題
根據聯邦文件,FDA今年對該工廠的檢查顯示,生產設施的設備和環境存在許多問題。 生產車間地板上的管道膠帶、車間地板上的積水、工作人員鞋子消毒劑未正確使用、烘乾機以及生產設備狀況惡劣。
以下地方檢測到克羅諾桿菌陽性:
灌裝線的包裝室中,在嬰兒奶粉中附送的量勺中檢測出細菌陽性。而就在FDA取樣的時候,還有大量的奶粉正在被包裝出庫。

生產車間地板中也發現了克羅諾桿菌,有人説工廠地上發現細菌並不是什麼大事,但是值得注意的是,生產區的工人在進出車間時從未正確為鞋子消毒,更沒有穿戴必要的無菌服。這種情況下,細菌非常容易被帶入生產區從而污染到奶粉。
早在2121年在FDA對雅培生產車間檢測時,就觀察到,工人在迴歸生產區前並未徹底洗手,正確更換無菌手套等,已經對其指出。

生產車間還開啓着風扇,導致大量細菌和灰塵直接接觸到奶粉表面,FDA給出的報告中顯示,2022年2月6日至2022年2月20日之前,工廠生產線中有20多處檢測到檢測到克羅諾桿菌。
以上生產車間的問題,可以追溯到2018年,細思極恐,有多少孩子有可能喝過感染克羅諾桿菌的奶粉。

03
雅培公司代表發聲明
雅培奶粉出事以來,雅培公司代表提供聲明:
“我們目前正在分析美國食品和藥物管理局(FDA)對我們密歇根州特吉斯工廠的奶粉生產進行檢查後發佈的483表格內容。對此結果,我們非常重視,並且我們正積極配合FDA調查,實施整改措施。雖然我們對FDA給出的結果努力的採取行動整改,但是重要的是,目前值得注意的是,並未在銷售給消費者的產品測試中發現坂崎克羅諾桿菌和沙門氏菌。此外,在斯特吉斯工廠(Sturgis facility)的非生產區發現的坂崎克羅諾桿菌的獨特基因組成與報告病例中的坂崎克羅諾桿菌並不匹配。在此之前,FDA已在本月早些時候將(我們產品)沙門氏菌案從調查中移除。”

雅培公司表示,會對未來每一批完成的配方奶粉進行廣泛的質量檢測,並加強對坂崎克羅諾桿菌、沙門氏菌和其他病原體的檢測。
來自華盛頓的民主黨參議員帕蒂·默裏(Patty Murray)表示,“FDA給出的報告披露了雅培公司生產車間的情況,令人深感不安,使得我們迫切的需要從雅培公司方得到答案。”上月,賓夕法尼亞州民主黨參議員鮑勃·凱西(Bob Casey)致信給雅培首席執行官羅伯特·福特(Robert Ford),要求其對幾款嬰兒配方奶粉產品受到細菌污染做出回應。

圖中為雅培首席執行官羅伯特·福特(Robert Ford)
04
坂崎克羅諾桿菌與沙門氏菌的危害
兒科急診科醫生Meghan Martin博士解釋説:“這兩種細菌都可能很嚴重,可能危及生命,尤其在這個年齡段”。
在約翰霍普金斯大學附屬兒童醫院,家長們紛紛帶着嬰兒來檢查,擔心嬰兒喝了可能受污染的奶粉。
專家説,父母應該注意觀察症狀。任何3個月以下的嬰兒發燒都需要進行評估,因為免疫系統還不夠強大。所以肯定的是,如果他們攝入了這種配方奶粉並似乎正在生病,就真的需要檢查看看。
坂崎克羅諾桿菌感染
一種可導致嚴重、危及生命的感染(敗血症)、壞死性結腸炎和腦膜炎的細菌。腦膜炎是一種保護大腦和脊柱的膜的炎症。嬰兒症狀可能包括營養不良、體温變化、皮膚和眼白髮黃、呼嚕聲和異常運動。FDA解釋説,這種細菌會導致腸道損傷,並可以通過血液傳播到其他器官。多達40%-50%的腦膜炎嬰兒最終會死亡。
大齡兒童和成人克羅諾桿菌感染往往較輕,但即使免疫系統很強,仍然有傷口或尿路感染。
檢查是否感染可能需要將血液、尿液和腦脊液提供給醫生,而非血液、汗水和眼淚,這取決於疑似感染的位置。
沙門氏菌感染****
導致胃腸道症狀,如腹瀉、發燒和腹部絞痛。患者可能會出現高燒、疼痛、頭痛、嗜睡、皮疹或尿血、便血。沙門氏菌病有時可能致命。
05
雅培公司產品持續召回中
雅培公司的產品持續被召回中。
FDA建議消費者不要繼續使用雅培公司所召回的產品,包括 Similac, Alimentum和EleCare配方奶粉。被召回的產品可以通過包裝底部的7-9位數字代表以及有效期來識別。

如果您手中購買的雅培產品的包裝上有下列數字,那麼則會包括在召回範圍內:
1. 產品代碼前兩位是數字22到37的;
2. 容器上代碼包含K8、SH或Z2的;
3. 保質期為2022年4月1日及之後的。

除了上述產品,雅培營養品還召回了批次代碼為27032K80(罐)/ 27032K800(箱)的雅培PM 60/40。

最後,世界衞生組織在2007年頒佈的《安全製備、貯存和操作嬰兒配方奶粉指導原則》中指出:在沖泡奶粉的時候,使用不低於70℃水調配嬰兒配方奶粉可顯著降低細菌感染的危險,然後再加涼水降到室温即可。

還要值得注意的是,在家裏也要保持奶粉存放和衝調區域及器具的衞生清潔,因為家中污染致病菌的概率也是很大的。
Taola